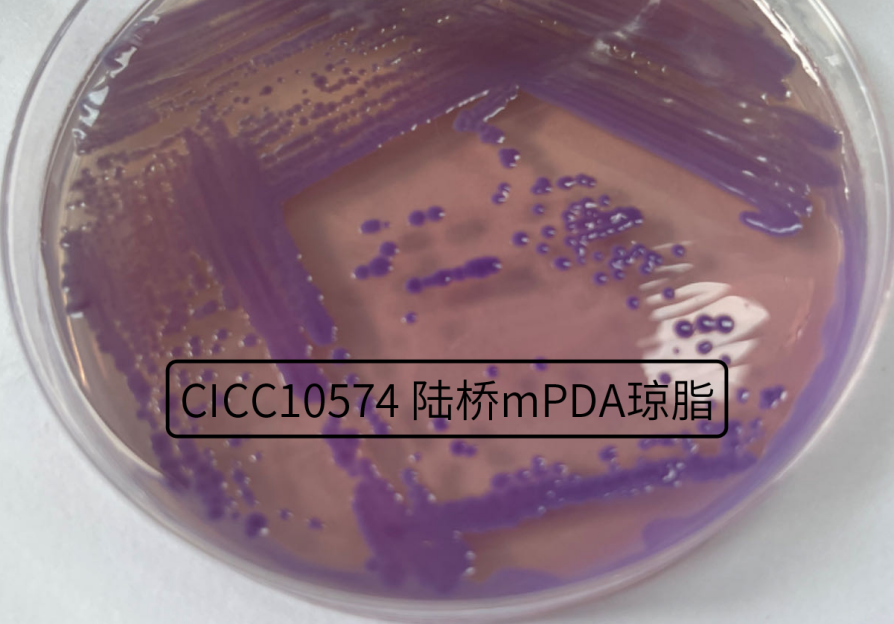

椰毒假單胞菌
酵米面黃桿菌
椰酵假單胞菌
椰毒假單胞菌酵米面亞種
唐菖蒲伯克霍爾德氏菌
一個擁有如此多名字,被譽為致病菌中戰(zhàn)斗菌,一旦中毒致死率高達(dá)40%-100%,能讓國家市場監(jiān)管總局發(fā)布預(yù)防中毒消費提示,該菌可謂醒目耀眼,它的名字不斷變化,“馬甲”眾多,經(jīng)常讓檢驗人員搞不清它的名稱,下面小編一層層揭開它的“面紗”。
???????????
圖1??唐菖蒲伯克霍爾德氏菌在mPDA平板上
?
不斷變換“馬甲”
首先,此菌為我國最先發(fā)現(xiàn)并特有的菌。它的出現(xiàn)與我國的飲食習(xí)慣相關(guān),東北地區(qū)習(xí)慣制作酵米面,吃此物偶見中毒,稱酵米面中毒。酵米面中毒解放前就有發(fā)生,解放后在黨的關(guān)懷下,1973年由衛(wèi)生部指派中國預(yù)防醫(yī)學(xué)科學(xué)院衛(wèi)生研究所調(diào)查病因。1974年在孟昭赫的主持下,成立酵米面中毒防治科研協(xié)作組,組成單位為:東北三省衛(wèi)生防疫站、中國預(yù)防醫(yī)學(xué)科學(xué)院衛(wèi)生研究所、哈爾濱醫(yī)科大學(xué)及白求恩醫(yī)科大學(xué)。1977年黑龍江省衛(wèi)生防疫站和中國預(yù)防醫(yī)學(xué)科學(xué)院衛(wèi)生研究所共同從黑龍江通河、巴彥兩起酵米面中毒樣品中分離出“黃色素桿菌”,經(jīng)自制培養(yǎng)基培養(yǎng)后,復(fù)制產(chǎn)毒效果較好,認(rèn)為此菌可能為酵米面中毒的病因。后經(jīng)協(xié)作組各單位反復(fù)驗證,一致認(rèn)為此桿菌是酵米面中毒的病因之一,明確了該菌在酵米面中毒病因?qū)W上的意義。1979年,“三站一所”共同對各地收集到從酵米面中毒樣品分離出的共40株該桿菌進(jìn)行研究,開展形態(tài)、生理生化和培養(yǎng)特性、毒性等試驗,證明它是我國細(xì)菌性食物中毒的一個新菌,此菌是我國酵米面中毒病因研究協(xié)作組經(jīng)過五年的共同努力,最終得以發(fā)現(xiàn)并確定,暫定名為酵米面黃桿菌(Flavobacterium ?farinofermentans ?nov ?sp)。 ???
1984年,劉秀梅首次報告了變質(zhì)銀耳中毒也是由該菌引起。胡文娟等分離出其主要毒素-黃桿菌毒素A即是已知的米酵菌酸(Bongkrekic acid)。
1987年,孟昭赫等將三株暫定名為酵米面黃桿菌的菌株與英國引進(jìn)的椰毒假單胞菌NCIB 9450進(jìn)行比對,從生理生化、血清學(xué)、產(chǎn)毒性能、DNA同源性等方面比對研究,證明這兩種菌除了生態(tài)分布(中國和印尼)和側(cè)金盞花醇試驗(酵米面黃桿菌可以分解側(cè)金盞花醇)結(jié)果不同,其他結(jié)果均相同,系同屬同種,但不屬于一個亞種,根據(jù)細(xì)菌命名原則,正式命名為椰毒假單胞菌酵米面亞種(Pseudomonas cocovenenans subsp.?farinofermentans )。
隨著DNA雜交、16S rDNA指紋及序列分析等分子生物學(xué)方法的應(yīng)用,1995年Gillis等根據(jù)rDNA結(jié)果,在假單胞菌科中建立新屬伯克霍爾德氏菌屬(Burkholderia),被歸入新屬的椰毒假單胞菌因此更名為椰毒伯克霍爾德氏菌(Burkholderia cocovenenans)。1999年,Coenye等通過全細(xì)胞蛋白分析和DNA雜交方法,指出椰毒伯克霍爾德氏菌應(yīng)歸類于唐菖蒲伯克霍爾德氏菌(Burkholderia??galdioli )。在國內(nèi),焦振泉、劉秀梅、楊瑞馥等也將國內(nèi)分離的椰毒假單胞酵米面亞種(簡稱椰酵假單胞菌)與唐菖蒲伯克霍爾德菌進(jìn)行比對研究,通過16SrDNA測序、DNA-DNA雜交等方法,證明椰酵假單胞菌與唐菖蒲伯克霍爾德氏菌,應(yīng)為同一菌種,又因是一個特殊病原型,故國家衛(wèi)健委2020年9月發(fā)布的GB 4789.29-2020《食品安全國家標(biāo)準(zhǔn) 食品微生物學(xué)檢驗 唐菖蒲伯克霍爾德氏菌(椰毒假單胞菌酵米面亞種)檢驗》,將該菌種更名為唐菖蒲伯克霍爾德氏菌(椰毒假單胞菌酵米面亞種)【Burkholderia gladioli (Pseudomonas cocovenenans subsp.?farinofermentans)】。
? ? 至此,該菌用過的馬甲都被曝光,小伙伴在查找該菌資料的時候,也應(yīng)注意不同年份需使用不同的名稱。
? ? 下為命名變化一覽圖:

打個小廣告,下期小編將談?wù)勗摼利惤k爛的“光環(huán)”成因。
參考資料:
1、《酵米面中毒病因的研究——發(fā)現(xiàn)一種新的食品中毒菌》酵米面中毒病因研究協(xié)作組,1980年.
2、《酵米面黃桿菌與椰毒假單胞菌的對比研究》孟昭赫,1987年.
3、《食品衛(wèi)生檢驗方法注解 微生物學(xué)部分》孟昭赫主編,1990年.
4、《變質(zhì)銀耳中毒的病因——實驗室研究》劉秀梅 1985年.
5、《椰毒假單胞菌酵米面亞種及米酵菌酸的研究進(jìn)展》王靜、劉秀梅 1996年.
6、《椰毒假單胞菌酵米面亞種16S rDNA序列測定與分析》焦振泉、劉秀梅 1998年.
7、《微孔板雜交法測定椰毒假單胞酵米面亞種的DNA-DNA同源性》焦振泉、劉秀梅、楊瑞馥、孟昭赫 ?2001年.
8、《椰毒假單胞菌酵米面亞種的鑒定、分型和溯源數(shù)據(jù)庫的建立》王崗 ?郭云昌指導(dǎo) 2012年.